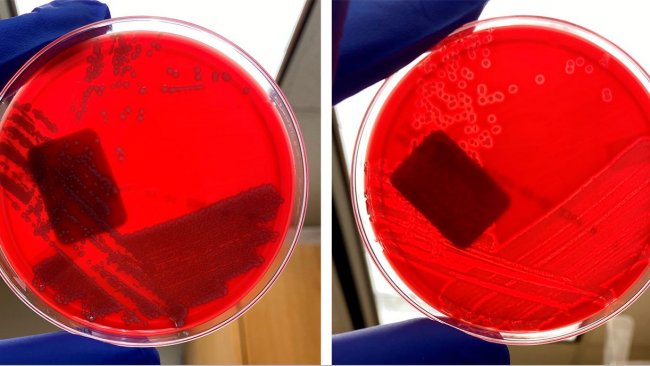
E. coli không tan huyết (trái) và E. coli tan huyết (phải).

Ngưỡng giá trị (cut-off) ảnh hưởng thế nào đến việc diễn giải kết quả ELISA?
Việc lựa chọn ngưỡng giá trị có ảnh hưởng trực tiếp đến độ nhạy, độ đặc hiệu và cũng như nguy cơ xuất hiện kết quả dương tính giả hoặc âm tính giả trong xét nghiệm ELISA. Chúng tôi sẽ giải thích lý do vì sao thời điểm lấy mẫu và mục đích xét nghiệm lại đóng vai trò quan trọng trong việc diễn giải kết quả.










Chuyên đề 2 của khóa Swine Academy – Sức khỏe ..
Hội chứng Rối loạn Sinh sản và Hô hấp trên heo (PRRS) hay thường ..
5% - PHÒNG NGỪA HIỆU QUẢ BỆNH CẦU TRÙNG HEO CON
..
"GIẢI MÃ" HIỆU QUẢ SÁT TRÙNG ƯU VIỆT CỦA VIRUSNIP CÙNG CHUYÊN GIA ..